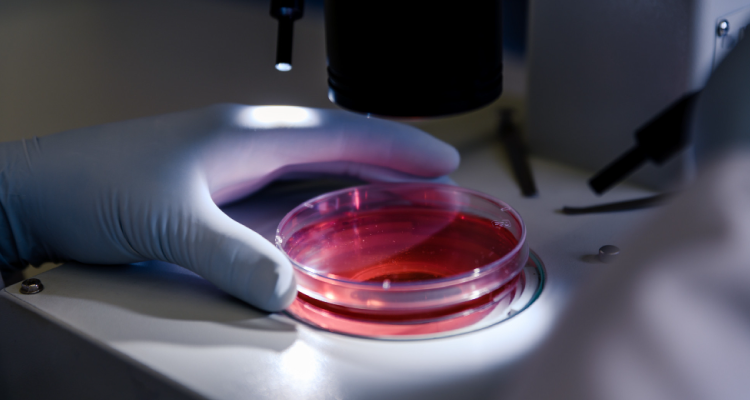

Biocenter Lab Guatemala
En Biocenter Lab, tu salud es nuestra prioridad. Somos un laboratorio clínico en Guatemala comprometido con brindar resultados confiables, atención personalizada y tecnología de vanguardia en cada análisis.
Paquetes de Servicios
Descubre nuestros paquetes clínicos con precios accesibles y resultados confiables, ideales para chequeos rutinarios o requerimientos laborales:
Chequeo Hepático
Tarjeta de Salud
Chequeo Diabético
Chequeo Básico
Perfil de Lípidos
Servicios de Laboratorio
En Biocenter Lab ofrecemos un amplio catálogo de análisis clínicos con altos estándares de calidad:

Hematología
Análisis de sangre para evaluar glóbulos rojos, blancos y plaquetas. Ideal para detectar anemias, infecciones y más.

Inmunohematología
Pruebas para compatibilidad sanguínea y detección de anticuerpos, esenciales en transfusiones y embarazos.
Coagulación
Procesos y pruebas de evaluación sobre el tiempo de coagulación para prevenir riesgos de sangrado o trombosis.

Heces
Análisis de sangre y otros exámenes de laboratorio para detección de parásitos intestinales y alteraciones digestivas.

Orina
Pruebas de función renal, detección de infecciones urinarias y otros indicadores generales de salud.

Pruebas Renales
Exámenes específicos para evaluar las funciones y estado de salud propia de los riñones en los pacientes.

Pruebas Especiales
Realizamos estudios más avanzados según requerimiento o necesidad médica solicitada de forma especifica.

Endocrinología
Nos expecializamos en la realización de exámenes hormonales para glándulas tiroides, páncreas, ovarios y más.

Infecciosas
Pruebas de laboratorio realizadas para la detección de virus, bacterias y enfermedades de transmisión sexual (ETS).
Acerca de nosotros
En Biocenter Lab, creemos que la salud comienza con un diagnóstico preciso y confiable. Somos un laboratorio clínico ubicado en la Ciudad de Guatemala, comprometido con brindar servicios de análisis clínicos con altos estándares de calidad, tecnología de vanguardia y atención humana.
Contamos con un equipo de profesionales altamente capacitados que garantizan resultados confiables, entregas oportunas y un acompañamiento integral en cada etapa del proceso. Atendemos tanto a pacientes particulares como a empresas, médicos y centros de salud que confían en nuestros servicios para el bienestar de sus pacientes.
Nos especializamos en una amplia gama de pruebas clínicas, desde análisis rutinarios hasta pruebas especializadas, siempre con un enfoque centrado en el paciente, la confidencialidad y la excelencia.
En Biocenter Lab trabajamos cada día con la misión de cuidar tu salud a través de la ciencia, el compromiso y la innovación.
«Excelente servicio desde que llegué. Me atendieron con mucha amabilidad y los resultados estuvieron listos incluso antes del tiempo estimado. ¡Muy profesionales y confiables!»
María Fernanda López
Llevo años haciéndome mis chequeos en Biocenter Lab y siempre he recibido una atención impecable. Tienen personal capacitado y tecnología moderna. 100% recomendado.»
Carlos Eduardo Mejía
«Tuve que hacerme un chequeo urgente y en Biocenter Lab me atendieron sin cita previa. Todo el proceso fue rápido, higiénico y el personal fue muy amable. Definitivamente volveré.»
Ana Patricia González
«Me sorprendió la rapidez con la que entregaron mis resultados y la claridad del informe. Además, el personal me explicó todo con paciencia. Se nota el compromiso. ¡Muy buen laboratorio!»
Luis Alejandro Ramírez